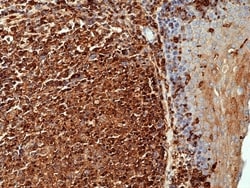
Invitrogen beta Actin Recombinant Rabbit Monoclonal Antibody (RM112) 100 &mu;L | Buy Online | Invitrogen&trade; | Fisher Scientific

Learn More
Invitrogen™ beta Actin Recombinant Rabbit Monoclonal Antibody (RM112)


Description
Specificity: reacts to beta-Actin (Actin, cytoplasmic 1). No cross reactivity with other isoforms of Actin. Recombinant rabbit monoclonal antibodies are produced using in vitro expression systems. The expression systems are developed by cloning in the specific antibody DNA sequences from immunoreactive rabbits. Then, individual clones are screened to select the best candidates for production. The advantages of using recombinant rabbit monoclonal antibodies include: better specificity and sensitivity, lot-to-lot consistency, animal origin-free formulations, and broader immunoreactivity to diverse targets due to larger rabbit immune repertoire.

Specifications
Specifications
| Antigen | beta Actin |
| Applications | ChIP Assay, Immunohistochemistry, Immunohistochemistry (Paraffin), Immunoprecipitation, Western Blot, Immunocytochemistry |
| Classification | Recombinant Monoclonal |
| Clone | RM112 |
| Concentration | 0.1 mg/mL |
| Conjugate | Unconjugated |
| Formulation | PBS with 1% BSA, 50% glycerol and 0.09% sodium azide |
| Gene | ACTB |
| Gene Accession No. | P60709, P60710, P60711 |
| Gene Alias | 0610041G09Rik; AA959943; AAT6; ACT; Act4; Act-4; ACT-5; ACTA; acta1; acta1b; ACTA2; Acta-2; ACTA3; actb; actb.L; actb1; actba; ACTC; actc1; Actc-1; actc1b; ACTE; Actg; ACTG1; Actg2; ACTGE; actin; actin alpha 1; actin alpha 1, skeletal muscle; actin alpha 1, skeletal muscle b; actin alpha 2, smooth muscle; actin alpha cardiac; actin alpha cardiac 1; actin alpha cardiac muscle 1; actin alpha cardiac muscle 1b; actin beta; actin gamma 1; actin gamma 2, smooth muscle; actin, alpha 1, skeletal muscle; actin, alpha 1b, skeletal muscle; actin, alpha 2, smooth muscle, aorta; Actin, alpha cardiac muscle 1; Actin, alpha cardiac muscle 1, intermediate form; actin, alpha cardiac muscle 1b; actin, alpha skeletal muscle; Actin, alpha skeletal muscle, intermediate form; actin, alpha, cardiac 1; actin, alpha, cardiac muscle; actin, alpha, cardiac muscle 1; actin, alpha, vascular smooth muscle; actin, aortic smooth muscle; Actin, aortic smooth muscle, intermediate form; actin, beta; actin, beta 1; actin, beta L homeolog; actin, beta, cytoplasmic; actin, cytoplasmic 1; Actin, cytoplasmic 1, N-terminally processed; Actin, cytoplasmic 2; Actin, cytoplasmic 2, N-terminally processed; actin, gamma 1; actin, gamma 2, smooth muscle, enteric; actin, gamma, cytoplasmic 1; actin, gamma-enteric smooth muscle; Actin, gamma-enteric smooth muscle, intermediate form; actin-like protein; Actl; ACTL3; Acts; ACTSA; ACTSG; Actsk-1; Actvs; Actx; AL023024; alpha actin 1; alpha-actin cardiac; alpha-actin-1; Alpha-actin-2; alpha-actin-3; alphac-actin; Alpha-cardiac actin; alphaSMA; alpha-smooth muscle actin; ASD5; ASMA; a-SMA; Bact; Bact; actin; B-actin; bactin1; bactin1 protein; bactzf; B-ACTZF; beta actin; beta cytoskeletal actin; beta-actin; beta-actin FE-3; beta-actin-1; BRWS1; BRWS2; cardiac muscle alpha actin 1; cardiofunk; cell growth-inhibiting gene 46 protein; Cfk; CFTD; CFTD1; CFTDM; CMD1R; CMH11; cytoplasmic 1; cytoplasmic beta-actin; cytoskeletal beta actin; cytoskeletal gamma-actin; cytoskeletal protein; deafness, autosomal dominant 20; deafness, autosomal dominant 26; DFNA20; DFNA26; E430023M04Rik; E51; epididymis luminal protein 176; fa27h01; fb83f06; gamma non-muscle actin; gamma-2-actin; Gamma-actin; gamma-enteric smooth muscle actin; GIG46; HEL-176; hm:zeh0631; I79_002310; I79_013242; I79_019066; LVNC4; MPFD; MYMY5; NEM1; NEM2; NEM3; nemaline myopathy type 3; PS1TP5-binding protein 1; PS1TP5BP1; SHPM; similar to beta actin; skeletal alpha actin; skeletal alpha1 actin; sma; SMalphaA; SMGA; smooth muscle alpha-actin; smooth muscle gamma-actin; vascular smooth muscle alpha-actin; VSCM; wu:fa27h01; wu:fb63d03; wu:fb83f06; wu:fd18f05; XELAEV_18045052mg; zeh0631 |
| Show More |
Safety and Handling
By clicking Submit, you acknowledge that you may be contacted by Fisher Scientific in regards to the feedback you have provided in this form. We will not share your information for any other purposes. All contact information provided shall also be maintained in accordance with our Privacy Policy.